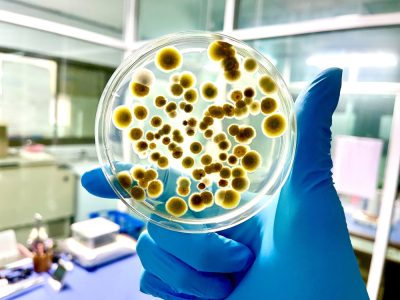

Οι ευρωπαίοι αγρότες απέναντι στην κλιματική αλλαγή
Οι ευρωπαίοι αγρότες απέναντι στην κλιματική αλλαγή
Οι αμπελώνες σε όλον τον κόσμο, και ιδιαίτερα στον Ευρωπαϊκό Νότο, πλήττονται βάναυσα από την κλιματική κρίση, ενώ πολλά αμπέλια είναι καταδικασμένα σε αφανισμό εξαιτίας των νέων κλιματικών συνθηκών. Πώς το αντιμετωπίζουν οι παραγωγοί;
«Δεν είμαι έτοιμος να αλλάξω δουλειά», λέει σε συνέντευξή του στον βρετανικό Guardian ο οινοποιός Στέλιος Μπουτάρης, επικεφαλής του Κτήματος Κυρ-Γιάννη, ενός από τους μεγαλύτερους αμπελώνες στην Ελλάδα, και νέος πρόεδρος του Συνδέσμου Ελληνικού Οίνου (ΣΕΟ). Αλλά, προσθέτει, «δεν μπορούμε να το κάνουμε όπως οι πατεράδες μας».
Πάντα δυναμικός και πολυσχιδής, ο Στέλιος Μπουτάρης είναι αποφασισμένος να συνεχίσει την παραγωγή του και να διατηρήσει την οικογενειακή επιχείρηση σε λειτουργία. Επισημαίνει ωστόσο ότι «η καμπύλη δεν φαίνεται καλή», καθώς η κλιματική κρίση ασκεί πίεση στους παραγωγούς σε όλη τη Μεσόγειο.
Ο ίδιος είναι ένας από τους χιλιάδες αγρότες στη νότια Ευρώπη που αγωνίζονται να συνεχίσουν να παράγουν στα εδάφη όπου οι πρόγονοί τους καλλιεργούσαν για δεκαετίες, ή ακόμα και αιώνες, καθώς όλο και πιο ακραία καιρικά φαινόμενα, όπως οι πυρκαγιές του φετινού καλοκαιριού, μαίνονται σε Ισπανία, Γαλλία και Ελλάδα, γράφει στον Guardian η Σάρα Μπάτλερ.
Οι αγώνες των ευρωπαίων αγροτών σημαίνουν ότι αναμένεται να συνεχιστούν οι αυξήσεις στις τιμές προϊόντων όπως το κρασί, οι ελιές, τα εσπεριδοειδή και τα λαχανικά, καθώς οι ξηρασίες, οι ξαφνικές πλημμύρες και οι υψηλές θερμοκρασίες επηρεάζουν τις παραδοσιακές καλλιέργειες στη Μεσόγειο.
Ο έλληνας οινοπαραγωγός εφαρμόζει νέες τακτικές για να αντιμετωπίσει το πρόβλημα, όπως εγκατάσταση συστημάτων άρδευσης και αποθήκευσης νερού και φύτευση περισσότερης βλάστησης ανάμεσα στα αμπέλια, ώστε να βοηθήσει τη γη να συγκρατεί περισσότερο νερό και να διατηρεί χαμηλές θερμοκρασίες.
Αγοράζει επίσης εκτάσεις σε υψηλότερες ζώνες και αναζητά διαφορετικές ποικιλίες σταφυλιών, που είναι πιο ανθεκτικές σε ακραίες καιρικές συνθήκες. Μάλιστα, μόλις επένδυσε 250.000 ευρώ σε αρδευτικά συστήματα και τώρα σχεδιάζει να δαπανήσει επιπλέον 200.000 ευρώ σε έναν αμπελώνα 400 στρεμμάτων στη Σαντορίνη.
Οι παραγωγοί σε όλη την Ευρώπη θα αναγκαστούν να μετακυλήσουν αυτό το επιπλέον κόστος στους καταναλωτές, με τη μορφή υψηλότερων τιμών, υποστηρίζει ο κ. Μπουτάρης μιλώντας στη δημοσιογράφο του Guardian. «Δεν θα είναι εύκολο να βρεις φθηνό κρασί. Παλαιότερα, ο Νότος της Γαλλίας, η Ισπανία και η Ελλάδα παρήγαν το φθηνό κρασί της Ευρώπης. Τώρα θα είναι πολύ δύσκολο να ανταγωνιστούμε σε επίπεδο τιμών» λέει.
Οι καταναλωτές αισθάνονται ήδη τις επιπτώσεις, καθώς οι ξηρασίες σε Ισπανία, Ιταλία και Πορτογαλία, από όπου το Ηνωμένο Βασίλειο προμηθεύεται μεγάλο μέρος των φρέσκων φρούτων και λαχανικών του κατά τη διάρκεια του φθινοπώρου και του χειμώνα, ωθούν προς τα πάνω τις τιμές αυτό το καλοκαίρι, σε μια εποχή που οι τιμές συνήθως έπεφταν.
Αυτό το καλοκαίρι, επισημαίνει η αγγλίδα δημοσιογράφος, ακόμη και οι αγρότες σε περιοχές του Ηνωμένου Βασιλείου έχουν πληγεί από μεγάλες περιόδους ξηρασίας που επηρεάζουν την παραγωγή δημητριακών, πατάτας, καρότων και μπρόκολου, τα οποία συνήθως δεν αρδεύονται.

Η κατάσταση, δε, αναμένεται να επιδεινωθεί πολύ περισσότερο εξαιτίας της κλιματικής κρίσης. Στην ΕΕ, η μέση ετήσια απώλεια για τις καλλιέργειες προβλέπεται να αυξηθεί έως και κατά δύο τρίτα έως το 2050, φτάνοντας τα 24,8 δισ. ευρώ, σύμφωνα με ανάλυση της Ευρωπαϊκής Τράπεζας Επενδύσεων (ΕΤΕπ) και της Ευρωπαϊκής Επιτροπής.
Μέχρι το 2050, η πιο σοβαρή αύξηση του κινδύνου ξηρασίας αναμένεται στην Ισπανία, στην Ιταλία και στην Ελλάδα, με περισσότερες από εννέα φορές περισσότερες ημέρες συνθηκών σοβαρής ξηρασίας κάθε χρόνο σε σύγκριση με το 1990, σύμφωνα με τις «μέσες εκτιμήσεις» της Διακυβερνητικής Επιτροπής για την Κλιματική Αλλαγή (IPCC).
Η Γαλλία, η Ιταλία, η Ισπανία και η Ρουμανία είναι πιθανό να σημειώσουν τις μεγαλύτερες απόλυτες αυξήσεις στις απώλειες καλλιεργειών, με τις μέσες ετήσιες απώλειες να αναμένεται να αυξηθούν κατά 64%, ή περισσότερο από 1 δισ. ευρώ, και με την ξηρασία να αποτελεί σημαντικό παράγοντα, σύμφωνα με την έκθεση της ΕΤΕπ και της Επιτροπής.
Το 2022, για παράδειγμα, οι αποδόσεις καλαμποκιού μειώθηκαν κατά 24% σε σχέση με το προηγούμενο έτος σε όλη την Ευρώπη, με την Ισπανία να υφίσταται το μεγαλύτερο ποσοστό απωλειών, ακολουθούμενη από τη Γαλλία, την Ιταλία και τη Ρουμανία.
Ο δρ Πίτερ Αλεξάντερ, καθηγητής Παγκόσμιων Συστημάτων Διατροφής στο Πανεπιστήμιο του Εδιμβούργου, λέει στον Guardian ότι είναι ήδη δυνατό να παρατηρηθεί η πορεία των καλλιεργειών προς τον Βορρά της Ευρώπης, με τους παραγωγούς σαμπάνιας να επενδύουν στο Ηνωμένο Βασίλειο και καλαμπόκι να καλλιεργείται στη Σκωτία.
Οι βρετανοί αγρότες πειραματίζονται με καλλιέργειες όπως τα φασόλια και τα ρεβίθια, τα οποία ιστορικά ήταν δύσκολο να καλλιεργηθούν, με την ελπίδα ότι τώρα μπορούν να ευδοκιμήσουν σε ένα θερμαινόμενο κλίμα. Μάλιστα, ένας αγρότης στο Εσεξ έχει φυτέψει πάνω από 1.000 ελαιόδεντρα με την υποστήριξη της Belazu, της εταιρείας premium προϊόντων διατροφής, μεταξύ άλλων και ελαιολάδου.
Ωστόσο, όσο προχωρά η κλιματική κρίση, τόσο πιο δύσκολη και δαπανηρή θα γίνεται η προσαρμογή. Ο δρ Αλεξάντερ λέει ότι αυτό το φαινόμενο είναι ήδη εμφανές σε πιο εξωτικές καλλιέργειες, οι οποίες απαιτούν πολύ συγκεκριμένες συνθήκες καλλιέργειας και τώρα βρίσκονται υπό πίεση, όπως ο καφές και το κακάο. «Στις χώρες με υψηλά εισοδήματα, αυτά τα προϊόντα είναι διαθέσιμα, αλλά σε λιγότερο προσιτές τιμές» εξηγεί.
Στο μεταξύ, στη νότια Ευρώπη, τα μικρά οικογενειακά αγροκτήματα αγωνίζονται να βρουν τους πόρους για να χρηματοδοτήσουν την προσαρμογή τους ώστε να συνεχίσουν να καλλιεργούνται. «Ηδη βλέπουμε να εγκαταλείπονται ελαιώνες και ανθρώπους που δεν αντέχουν πλέον να είναι αγρότες», επισημαίνει η Σάρα Βασόν εκ μέρους της εταιρείας ελαιολάδου Citizens of Soil, η οποία συνεργάζεται με ανεξάρτητους ελαιοπαραγωγούς σε όλη τη Μεσόγειο.
Η Βασόν προσθέτει ότι οι αγρότες αναζητούν πολλούς τρόπους για να συνεχίσουν, από την άρδευση έως νέες ποικιλίες, αλλά «αυτές είναι μεγάλες επενδύσεις για μικρούς αγρότες, που ζουν ήδη στα όρια της φτώχειας και είναι δύσκολο να βρουν κρατική χρηματοδότηση για αυτά τα πράγματα».
Ο Στέλιος Μπουτάρης λέει ότι στην Ελλάδα υπάρχουν περιοχές όπου οι μικροί αγρότες έχουν ήδη εγκαταλείψει τη γη τους και έχουν επιλέξει άλλους τρόπους ζωής, καθώς η γεωργία έχει γίνει πολύ δύσκολη.
Ακόμη, σύμφωνα με τον Αλεξ Φερνάντεθ Πόουλουσεν, διευθυντή της Good Stuff International –η οποία συντονίζει ένα πρόγραμμα συλλογικής ύδρευσης στη λεκάνη απορροής του ποταμού Γουαδαλκιβίρ στη νότια Ισπανία–, είναι απαραίτητη η ανάληψη δράσης, καθώς στην Ισπανία αποθηκεύεται λιγότερο από το μισό νερό και η ζήτηση είναι πολύ υψηλή.
Λέει ότι η έκταση της καλλιεργούμενης γης στην περιοχή είναι πιθανό να μειωθεί, καθώς ορισμένα αγροκτήματα πωλούνται σε επενδυτικά κεφάλαια για την κατασκευή φωτοβολταϊκών πάρκων ή μετατρέπονται από οπωρώνες εσπεριδοειδών ή αβοκάντο σε καλλιέργειες που απαιτούν λιγότερο νερό, όπως σιτάρι, καλαμπόκι, δημητριακά ή ελιές.
Επειτα από αρκετά χρόνια ξηρασίας στη νότια Ισπανία, δρομολογούνται μεγάλα έργα για την ανάπτυξη μιας συντονισμένης προσέγγισης για την πιο αποτελεσματική αποθήκευση και χρήση του νερού, συμπεριλαμβανομένων νέων μορφών άρδευσης. «Τα πράγματα πρέπει να αλλάξουν λόγω της κλιματικής κατάστασης, αλλά υπάρχει πολλή προληπτική καινοτομία και προσπάθεια», επισημαίνει στον Guardian ο Αλεξ Φερνάντεθ Πόουλουσεν.
Ο Γουόλτερ Ζάνρε, διευθύνων σύμβουλος του βρετανικού παραρτήματος της μάρκας ελαιολάδου Filippo Berio, αναφέρει ότι η παραγωγή στην Ανδαλουσία, στην Απουλία, στη Σικελία, στην Ελλάδα, στην Τυνησία και στην Τουρκία αναμένεται να επηρεαστεί από τις υψηλότερες μέσες θερμοκρασίες και τις λιγότερες βροχοπτώσεις. «Υπάρχουν πολλά έργα για εξοικονόμηση νερού και χρήση του για άρδευση. Αλλά για να εξοικονομηθεί νερό πρέπει πρώτα να βρέξει. Φέτος είχαμε χειμερινές βροχές, αλλά τα προηγούμενα τρία χρόνια ουσιαστικά υπήρξε ξηρασία», τονίζει.
Λόγω ανησυχιών για τις μελλοντικές προμήθειες, τα τελευταία πέντε χρόνια η Filippo Berio έχει επενδύσει σε δεξαμενές όπου αποθηκεύει 3.000 τόνους λαδιού επιπλέον, και έχει ενοικιάσει προσωρινά χώρο για ακόμη 1.000 τόνους, ενώ παράλληλα έχει στραφεί σε ένα ευρύτερο φάσμα πηγών ελαιολάδου, συμπεριλαμβανομένης της Λατινικής Αμερικής.
Ο Λάμπερτ φαν Χόρεν, αναλυτής της συνεταιριστικής Rabobank, λέει ότι ο χρηματοοικονομικός όμιλος προβλέπει πως τα επόμενα πέντε χρόνια δεν θα υπάρξει αύξηση της γεωργικής παραγωγής ανά εκτάριο στην Ευρώπη, τερματίζοντας δεκαετίες βελτίωσης, που υποστηρίχθηκαν από την αυξημένη αποδοτικότητα και τα καλύτερα λιπάσματα.
Ωστόσο, αυτό σημαίνει υψηλότερες τιμές: «Τα τελευταία πέντε χρόνια οι τιμές των φρέσκων προϊόντων έχουν συμβαδίσει με τον πληθωρισμό, έχουν ακόμη και ξεπεράσει τον γενικό πληθωρισμό. Τα επόμενα πέντε χρόνια αναμένουμε ότι τα τρόφιμα θα ακολουθήσουν τουλάχιστον τον γενικό πληθωρισμό», λέει.
Και προσθέτει: «Οι αγρότες θα πάρουν υψηλότερες τιμές. Και τις χρειάζονται επειδή οι εισροές τους γίνονται πιο ακριβές». Αυτό θα μπορούσε να περιλαμβάνει από την κατασκευή περισσότερων σκιάστρων ή θερμοκηπίων όπου οι θερμοκρασίες και η ροή νερού μπορούν να ελέγχονται καλύτερα, ανεξάρτητα από το κλίμα, έως την κατασκευή περισσότερων αποθηκευτικών χώρων.
Στην Ελλάδα, τέλος, έπειτα από δύο δύσκολα χρόνια, μέχρι στιγμής το 2025 είναι μια αξιοπρεπής χρονιά για πολλούς οινοπαραγωγούς. Ωστόσο, με τις πυρκαγιές να μαίνονται, πολλοί μικροί αγρότες σκέφτονται το μέλλον τους. Ο Στέλιος Μπουτάρης, πάντως, είναι αποφασισμένος να συνεχίσει: «Πρέπει να υπάρχει ένας τρόπος να το κάνουμε και θέλω να δείξω ότι μπορεί να γίνει», λέει στον Guardian.
Ακολουθήστε το Protagon στο Google News